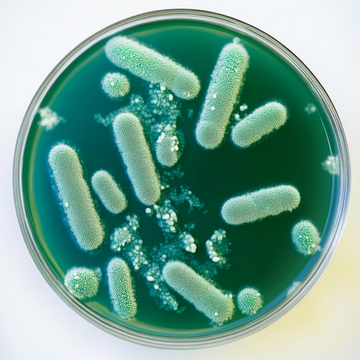

Serving Size is 1 Capsule
Pro-X10™ — Advanced Probiotic Supplement with Prebiotics

Swipe to view more
Serving Size is 1 Capsule
Pro-X10™ — Advanced Probiotic Supplement with Prebiotics







Select your money-saving option below:
Choose Your Package
Health Journeys Shared by Our Customers

I have stomach problems all the time and this helps with bloating and heartburn. I recommend this product to anyone who has stomach problems.

I feel the difference and I’m quite satisfied. Glad I started when I did — should have started earlier!

It helped me with having to take antibiotics. I was a mess until I took this and it helped me feel back to normal.

I feel this product has truly helped me. I feel much better after taking this for almost one month. I will buy again.

I have stomach problems all the time and this helps with bloating and heartburn. I recommend this product to anyone who has stomach problems.

I feel the difference and I’m quite satisfied. Glad I started when I did — should have started earlier!

It helped me with having to take antibiotics. I was a mess until I took this and it helped me feel back to normal.

I feel this product has truly helped me. I feel much better after taking this for almost one month. I will buy again.
Powerful Support for Gut Health, Digestion & Immunity
Support your digestive balance and immune health with advanced probiotics and prebiotics for a healthier, more energized you.


Restore Healthy Gut Flora
Provides 10 billion CFUs daily (at time of manufacture) from six research-backed probiotic strains, including DE111® Bacillus subtilis, all protected with acid-resistant microencapsulation—and fueled by PreforPro® prebiotic for enhanced growth.
Support Holistic Digestive Health
Helps maintain a healthy balance of gut bacteria, support nutrient absorption, and strengthen the gut barrier for overall digestive health.
Support Immune System Function
70% of your immune system resides in your gut—Pro-X10™ helps strengthen this vital defense.
Relieve Gas, Bloating & Discomfort
Promotes digestive comfort by helping to reduce occasional gas and bloating.
Promote Digestive Comfort & Regularity
Supports a healthy gut environment to help maintain regular bowel movements and ease occasional digestive discomfort.
Simplify Your Gut Health Routine
BioTRUST Pro-X10™ makes it easy to support your digestion, balance your gut microbiome, and strengthen your immune system—all with one simple daily capsule.

Take Daily, No Hassle
Just two easy-to-swallow capsules provide symbiotic support.

Boost with Advanced Synbiotic Support
Delivers 10 billion CFUs daily with Pro-X10™ microencapsulation for maximum probiotic survival—plus PreforPro®, a unique non-fiber prebiotic. Together, they form a powerful synbiotic for optimal gut health.

Feel Healthier, From the Inside Out
Supports digestive comfort, reduced bloating, stronger immunity, and overall daily well-being.

Powerful Ingredients, Real Results
Support digestive health, balance gut flora, and enhance immune function—feel the difference.

Multi-Strain Probiotic Blend
A robust blend of six probiotic strains delivering 10 billion CFUs daily (at time of manufacture)—clinically shown to support digestion, gut balance, and immune health.
Bacillus subtilis (DE111®)
A clinically studied, heat- and acid-resistant strain that survives stomach acid to reach the gut alive—backed by research for digestive balance, gut flora, and immune support.

PreforPro® Prebiotic Blend
A next-generation, non-fiber prebiotic that fuels probiotics without the gas or bloating of fiber-based prebiotics—making Pro-X10™ a complete synbiotic.
Clinically-Studied Benefits of Probiotics + Prebiotics
Real results backed by science—for optimal digestion, gut balance, and immune health.
Digestion
Helps break down food efficiently for improved nutrient absorption.
Occasional Gas & Bloating
Promotes digestive comfort and reduces abdominal discomfort.
Gut Flora
Encourages the growth of beneficial bacteria with daily multi-strain probiotic use.
Advantage
Combines probiotics with PreforPro®, a non-fiber prebiotic that nourishes healthy bacteria without bloating.
Us vs Them
Support digestion, gut balance, and immune health with a cutting-edge, science-backed probiotic formula.



Clinically studied multi-strain probiotic (10 B CFU)
May use generic or unproven strains
PreforPro® non-fiber prebiotic included (synbiotic)
Often lacks prebiotics, or uses fiber types that cause bloating
Microencapsulation tech protects probiotics through digestion
May not survive stomach acid or bile
Supports digestion, immune health & gut balance
Often targets just one benefit
Built for Strong, Balanced Gut Health
Support digestion and immunity today for total wellness that lasts tomorrow.

Clinically Researched Strains & Prebiotics
Features DE111® (Bacillus subtilis) and PreforPro® — a unique probiotic + prebiotic blend designed to survive stomach acid and promote gut balance.
Supports Digestive & Immune Health
Promotes regular digestion, gut balance, and immune defense — helping you feel your best every day.
Advanced Delivery Technology
Microencapsulation protects probiotics from heat, moisture, and stomach acid, helping more of them reach your intestines alive and active.
Pure & Clean Formula
Made without unnecessary fillers, artificial colors, or preservatives — just high-quality ingredients your body can trust.
Feel the Difference in 60 Days — Or Your Money Back!
We're so confident in Pro-X10™ that we back it with our 60-Day Total Satisfaction Guarantee. Support your digestive health with portent probiotics. If you don't see or feel a noticeable difference in 60 days, simply return the product for a refund, no questions asked.
No risk. No guesswork. Just results — or your money back.
Customer Reviews
See what our customers are saying about Pro-X10™ — Advanced Probiotic Supplement with Prebiotics
Frequently Asked Questions
Have any more questions? Let us know!